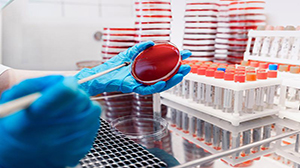
AX

لوله های خونگیری SST حاوی Clot Activator + GEL
لوله های خونگیری SST حاوی فعال کننده لخته خون و ژل پلیمری می باشند. این لوله ها جهت تسریع در فرایند انعقاد، حاوی یک فعال کننده انعقاد بوده که بوسیله میکرواسپری بر روی دیواره داخلی لوله اسپری و خشک گردیده است.
ژل پلیمری نیز دارای ویسکوزیته خاصی است که طی سانتریفوژ یک مانع غیرقابل نفوذ بین سرم و لخته خون ایجاد کرده و از آلودگی سرم با اجزاء سلولی جدا شده جلوگیری می کند. به عنوان مثال در مورد آنالیت های خاصی مانند فسفر، پتاسیم و گلوکز، باید در عرض چند ساعت سرم از اجزاء سلولی جدا گردد درغیر اینصورت باعث ایجاد نتایج کاذب می شود که با وجود این ژل دیگر تماسی بین سرم و اجزاء سلولی وجود ندارد.
مزیت اصلی لوله های ژلدار نسبت به لوله های بدون ژل در واقع همان سد غیرقابل نفوذ بین سرم و لخته خون است که منجر به پایداری بهتر آنالیت ها می شود. مزیت دیگر لوله های ژلدار نسبت به لوله های بدون ژل، بهینه سازی جریان کار با کوتاه شدن زمان سانتریفوژ، همچنین پردازش و بایگانی نمونه در همان لوله اولیه و بدون نیاز به لوله دوم می باشد.
حداقل زمان توصیه شده برای ایجاد لخته در مورد لوله های SST سیناجکت، در بیمارانی که داروهای ضد انعقاد مصرف نکرده اند، حداقل 30 دقیقه می باشد.
ژل استفاده شده در لوله های SST سیناجکت با دور سانتریفوژ 3500 به مدت 5 دقیقه بین سرم و لخته خونی قرار می گیرد.
لوله های SST سیناجکت باید در دمای 4-28 درجه سانتی گراد و دور از تابش مستقیم نور خورشید نگهداری گردند.
بهینه جداسازی سرم از لخته خون در دمای 20-25 درجه سانتی گراد بدست می آید.
از لوله های SST حاوی ژل و فعال کننده انعقاد، جهت تست های بیوشیمی، میکروبیولوژی، سرولوژی و ایمونولوژی می توان استفاده کرد.